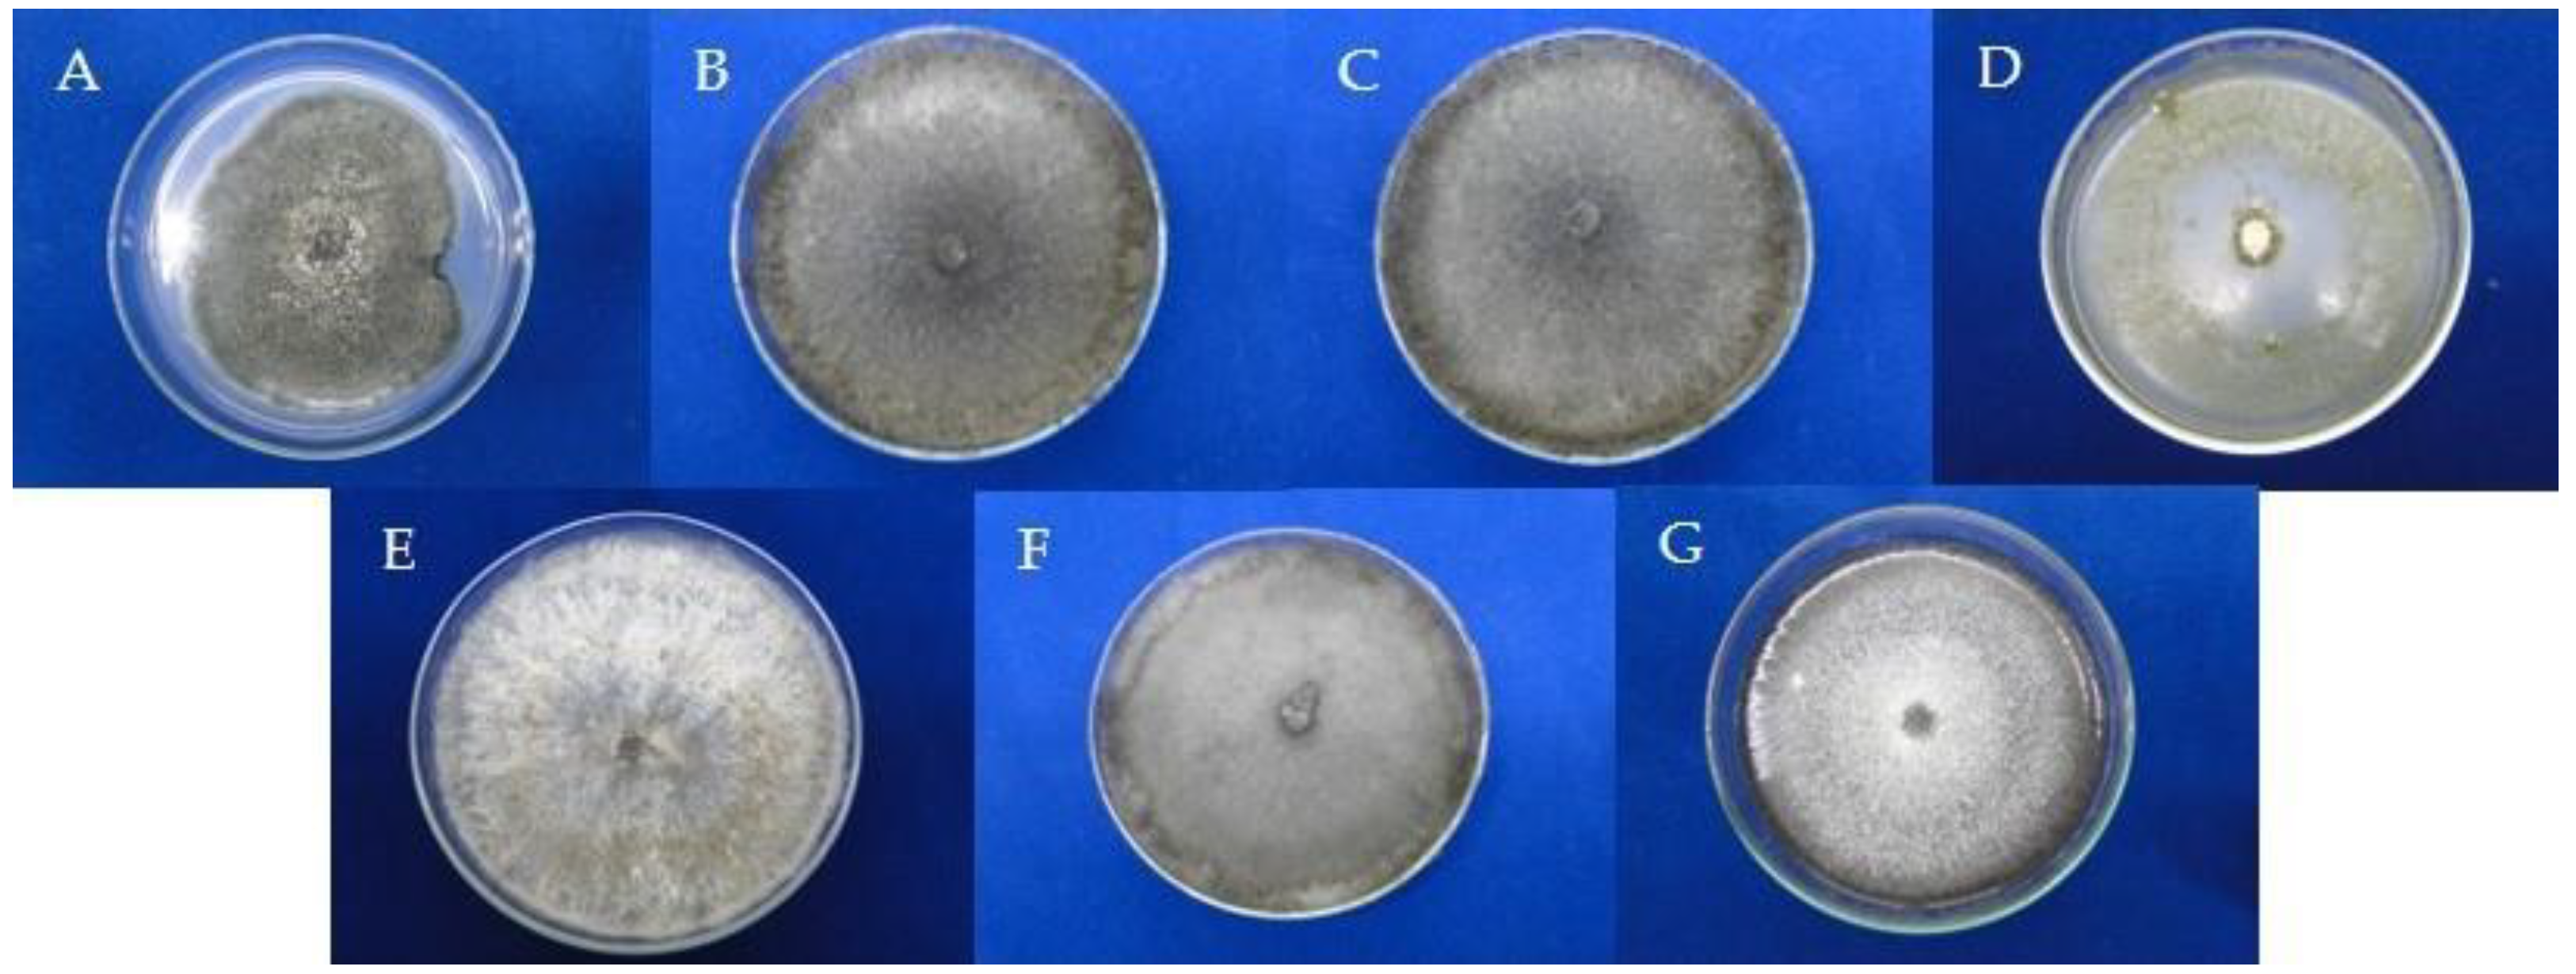
Agronomy 12 01690 g001
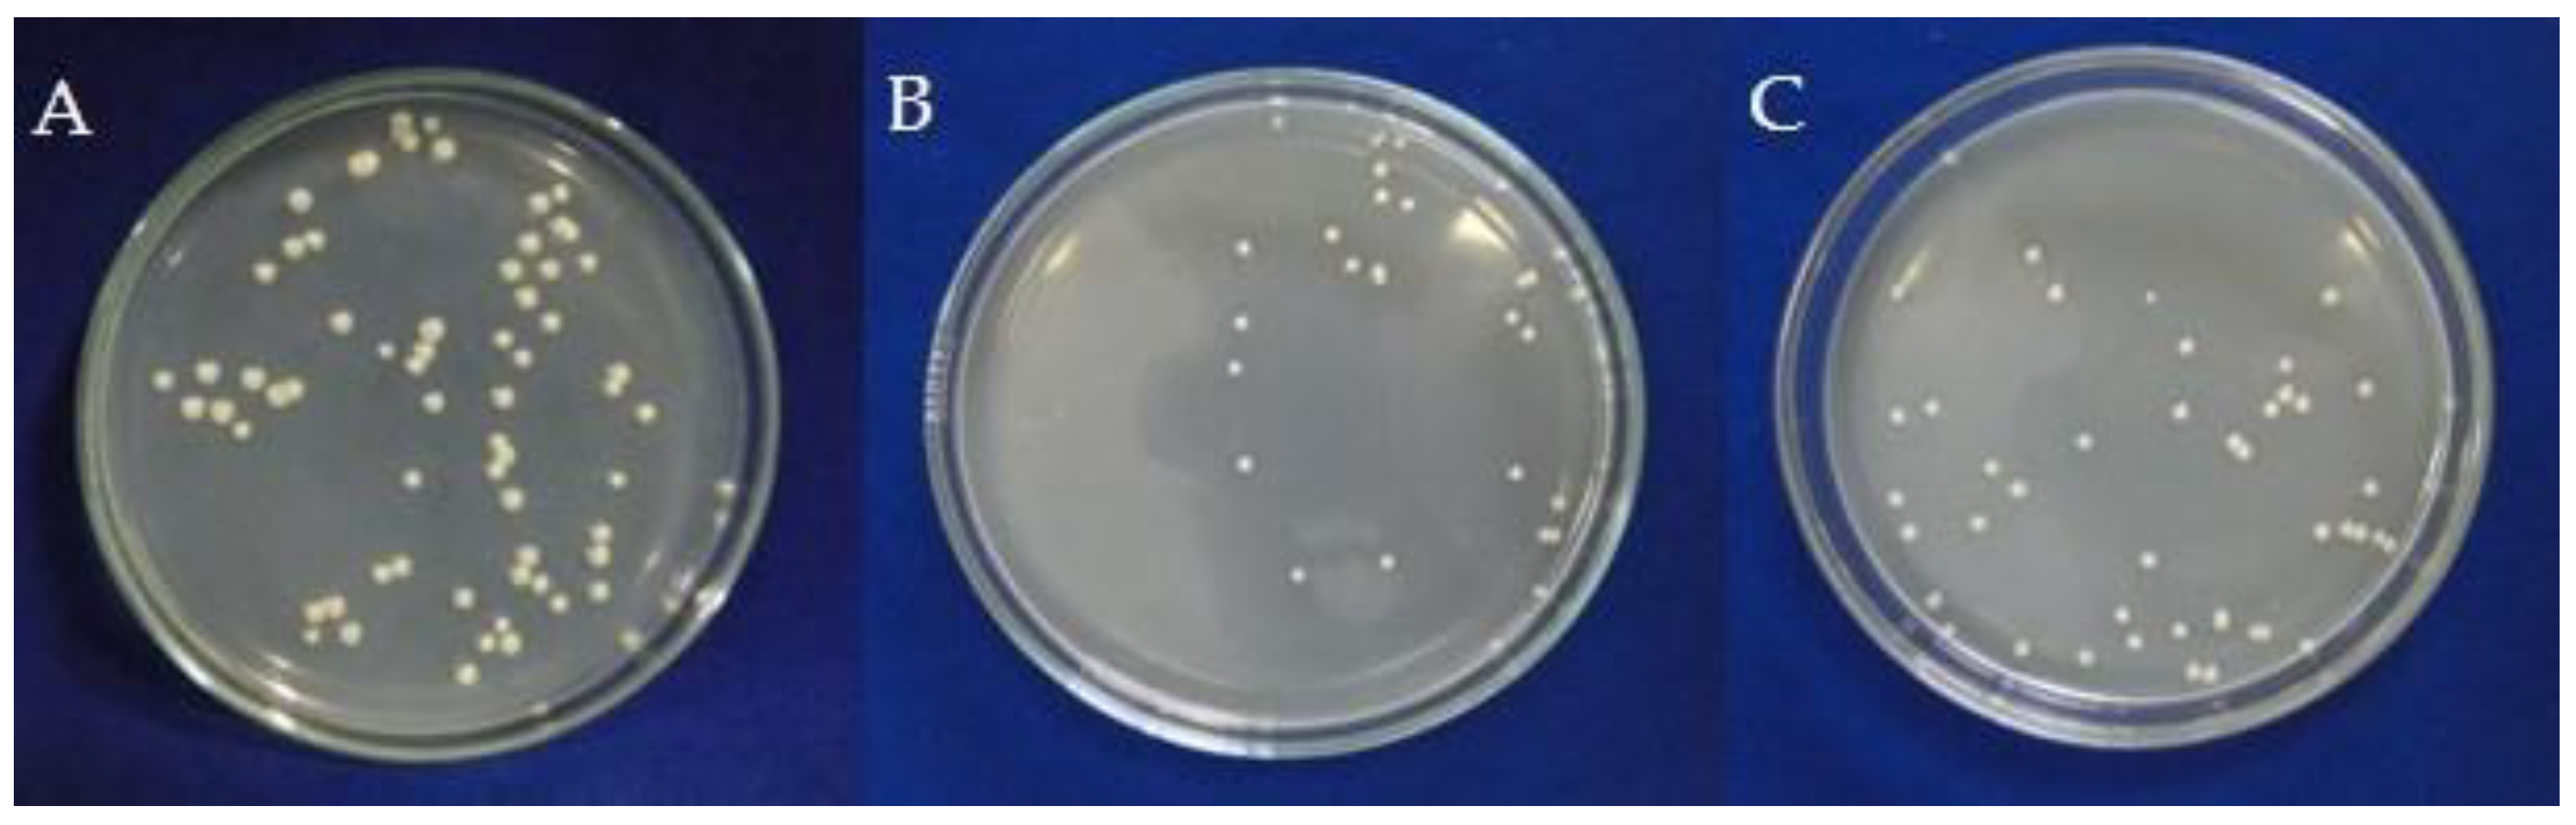
Agronomy 12 01690 g002

Bioprospecting the Antibacterial Activity of Endophytic Fungi from Noni (Morinda citrifolia) against Bacterial Spot of the Passion Fruit Tree
Abstract
:1. Introduction
2. Materials and Methods
2.1. Microorganisms
2.2. Isolation of Endophytic Fungi
2.3. Molecular Identification of Selected Endophytic Fungi
2.4. Small-Scale Extracts of Fungi
2.5. In Vitro Antibacterial Assay of Small-Scale Fungal Extracts
2.6. Cultivation of the Guignardia Mangiferae NF17 in Rice
2.7. Obtaining Extracts and the Isolation of the Compounds from Guignardia Mangiferae NF17
2.8. NMR Analysis
2.9. Antimicrobial Assays of Fungal Extracts and Isolated Compounds in 96-Well Plates
3. Results
3.1. Identification of Fungi and Antimicrobial Assays with Small-Scale Extracts
3.2. Identification of Isolated Compounds
3.3. Antimicrobial Assays for the ACN Extract and Compounds S1 and S2
4. Discussion
5. Conclusions
Supplementary Materials
Author Contributions
Funding
Institutional Review Board Statement
Informed Consent Statement
Data Availability Statement
Acknowledgments
Conflicts of Interest
References
- IBGE. Instituto Brasileiro de Geografia e Estatística. Produção Agrícola Municipal Culturas Temporárias e Permanentes. 2020. Available online: https://www.ibge.gov.br/estatisticas/economicas/agricultura-e-pecuaria/9117-producao-agricola-municipal-culturas-temporarias-e-permanentes.html?=&t=resultados (accessed on 28 April 2022).
- Nogueira, I.; Costa, A.P.; Peixoto, J.R.; Vilela, M.S. Reaction of Sour Passion Fruit Lineages and Hybrids to Bacterial Spot Caused by Xanthomonas axononopodis pv. passiflorae Under Protected Cultivation and Field Conditions. J. Agric. Sci. 2021, 13, 112–121. [Google Scholar]
- De Oliveira, L.C.; Ishida, A.K.N.; Da Silva, C.T.B.; Carvalho, J.M.; Feitosa, A.O.; Marinho, P.S.B.; Marinho, A.M.R. Antibacterial activity of austdiol isolated from Mycoleptodiscus indicus against Xanthomonas axonopodis pv. passiflorae. Rev. Virtual Quim. 2019, 11, 596–604. [Google Scholar] [CrossRef]
- Mostafalou, S.; Abdollahi, M. Pesticides: An update of human exposure and toxicity. Arch. Toxicol. 2017, 91, 549–599. [Google Scholar] [CrossRef]
- Almeida, E.S.; Oliveira, D.; Hotza, D. Properties and Applications of Morinda citrifolia (Noni): A Review. Compr. Rev. Food Sci. Food Saf. 2019, 18, 883–909. [Google Scholar] [CrossRef] [Green Version]
- Assi, R.A.; Darwis, Y.; Abdulbaqi, I.M.; Khan, A.A.; Vuanghao, L.; Laghari, M.H. Morinda citrifolia (Noni): A comprehensive review on its industrial uses, pharmacological activities, and clinical trials. Arab. J. Chem. 2017, 10, 691–707. [Google Scholar] [CrossRef]
- Oliveira, L.C.; Ishida, A.K.N.; Silva, C.T.B.; Marinho, P.S.B.; Marinho, A.M.R. Atividade antibacteriana de extratos de Morinda citrifolia L. (noni) contra Xanthomonas axonopodis pv. passiflorae. Rev. Cuba. Plantas Med. 2018, 23, 1–13. [Google Scholar]
- Fontana, D.C.; Paula, S.; Torres, A.G.; Souza, V.H.M.; Pascholati, S.F.; Schmidt, D.; Dourado Neto, D. Endophytic fungi: Biological control and induced resistance to phytopathogens and abiotic stresses. Pathogens 2021, 10, 570. [Google Scholar] [CrossRef]
- Newman, D.J.; Cragg, G.M. Natural products as sources of new drugs over the nearly four decades from 01/1981 to 09/2019. J. Nat. Prod. 2020, 83, 770–803. [Google Scholar] [CrossRef]
- Newman, D.J.; Cragg, G.M. Plant endophytes and epiphytes: Burgeoning sources of known and “Unknown” cytotoxic and antibiotic agents? Planta Med. 2020, 86, 891–905. [Google Scholar] [CrossRef] [Green Version]
- Sudha, V.; Govindaraj, R.; Baskar, K.; Al-Dhabi, N.A.; Duraipandiyan, V. Biological properties of endophytic fungi. Braz. Arch. Biol. Technol. 2016, 59, e16150436. [Google Scholar] [CrossRef] [Green Version]
- El-Baky, N.A.; Amara, A.A.A.F. Recent approaches towards control of fungal diseases in plants: An updated review. J. Fungi 2021, 7, 900. [Google Scholar] [CrossRef]
- Wu, L.S.; Dong, W.G.; Si, J.P.; Liu, J.J.; Zhu, Y.Q. Endophytic fungi, host genotype, and their interaction influence the growth and production of key chemical components of Dendrobium catenatum. Fungal Biol. 2020, 124, 864–876. [Google Scholar] [CrossRef] [PubMed]
- Rodrigues, G.N.; Alvarenga, N.; Vacondio, B.; Vasconcellos, S.P.; Passarini, M.R.Z.; Seleghim, M.H.R.; Porto, A.L.M. Biotransformation of methyl parathion by marine-derived fungi isolated from ascidian Didemnum ligulum. Biocatal. Agric. Biotechnol. 2016, 7, 24–30. [Google Scholar] [CrossRef]
- Saitou, N.; Nei, M. The neighbor-joining method: A new method for reconstructing phylogenetic trees. Mol. Biol. Evol. 1987, 4, 406–425. [Google Scholar] [CrossRef] [PubMed]
- Tamura, K.; Stecher, G.; Peterson, D.; Filipski, A.; Kumar, S. MEGA6: Molecular evolutionary genetics analysis version 6.0. Mol. Biol. Evol. 2013, 30, 2725–2729. [Google Scholar] [CrossRef] [PubMed] [Green Version]
- Kado, C.I.; Heskett, M.G. Selective media for isolation of Agrobacterium, Corynebacterium, Erwinia, Pseudomonas and Xanthomonas. Phytopathology 1970, 60, 969–976. [Google Scholar] [CrossRef]
- Scott, A.; Knott, M. Acluster-analysis method for grouping means in the analysis of variance. Biometrics 1974, 30, 507–512. [Google Scholar] [CrossRef] [Green Version]
- Gabrielson, J.; Hart, M.; Jarelöv, A.; Kuhn, I.; Mckenzie, D.; Möllby, R. Evaluation of redox indicators and the use of digital scanners and spectrophotometer for quantification of microbial growth in microplates. J. Microbiol. Methods. 2002, 50, 63–73. [Google Scholar] [CrossRef]
- Sun, R.; Miao, F.; Zhang, J.; Wang, G.; Yin, X.; Ji, N. Three new xanthone derivatives from an algicolous isolate of Aspergillus wentii. Magn. Reson. Chem. 2013, 51, 65–68. [Google Scholar] [CrossRef]
- Goddard, M.; Mottier, N.; Jeanneret-Gris, J.; Christen, D.; Tabacchi, R.; Abou-Mansour, E. Differential production of phytotoxins from Phomopsis sp. from grapevine plants showing esca symptoms. J. Agric. Food Chem. 2014, 62, 8602–8607. [Google Scholar] [CrossRef]
- Marin, V.R.; Ferrarezi, J.H.; Vieira, G.; Sass, D.C. Recent advances in the biocontrol of Xanthomonas spp. World J. Microbiol. Biotechnol. 2019, 35, 72. [Google Scholar] [CrossRef] [PubMed]
- Deshmukh, S.K.; Dufossé, L.; Chhipa, H.; Saxena, S.; Mahajan, G.B.; Gupta, M.K. Fungal endophytes: A potential source of antibacterial compounds. J. Fungi 2022, 8, 164. [Google Scholar] [CrossRef] [PubMed]
- Slama, H.B.; Bouket, A.C.; Alenezi, F.N.; Pourhassan, Z.; Golińska, P.; Tomasz Oszako, T.; Belbahri, L. Potentials of endophytic fungi in the biosynthesis of versatile secondary metabolites and enzymes. Forests 2021, 12, 1784. [Google Scholar] [CrossRef]
- Purić, J.; Vieira, G.; Cavalca, L.B.; Sette, L.D.; Ferreira, H.; Vieira, M.L.C.; Sass, D.C. Activity of Antarctic fungi extracts against phytopathogenic bacteria. Lett. Appl. Microbiol. 2018, 66, 530–536. [Google Scholar] [CrossRef]
- Tonucci-Zanardo, N.M.; Pascholati, S.F.; Di Piero, R.M. In vitro antimicrobial activity of aqueous extracts from Lentinula edodes isolates against Colletotrichum sublineolum and Xanthomonas axonopodis pv. passiflorae. Summa Phytopathol. 2015, 41, 13–20. [Google Scholar] [CrossRef] [Green Version]
- Mai, N.; Matainaho, T.; Rai, P.P.; Barrows, L.R. Antimicrobial activity of endophytes in six medicinal plants collected in the Central Province, Papua New Guinea. Pac. J. Med. Sci. 2013, 11, 57–69. [Google Scholar]
- Ataides, D.; Pamphile, J.A.; Garcia, A.; Ribeiro, M.A.S.; Polonio, J.C.; Sarragiotto, M.H.; Clemente, E. Curvularin produced by endophytic Cochliobolus sp. G2-20 isolated from Sapindus saponaria L. and evaluation of biological activity. J. Appl. Pharm. Sci. 2018, 8, 032–037. [Google Scholar] [CrossRef] [Green Version]
- Flores, A.C.; Pamphile, J.A.; Sarragiotto, M.H.; Clemente, E. Production of 3-nitropropionic acid by endophytic fungus Phomopsis longicolla isolated from Trichilia elegans A. JUSS ssp. elegans and evaluation of biological activity. World J. Microbiol. Biotechnol. 2013, 29, 923–932. [Google Scholar] [CrossRef]
- Pina, J.R.S.; Silva-Silva, J.V.; Carvalho, J.M.; Bitencourt, H.R.; Watanabe, L.A.; Fernandes, J.M.P.; Souza, G.E.; Aguiar, A.C.C.; Guido, R.V.C.; Almeida-Souza, F.; et al. Antiprotozoal and antibacterial activity of ravenelin, a xanthone isolated from the endophytic fungus Exserohilum rostratum. Molecules 2021, 26, 3339. [Google Scholar] [CrossRef]
- Kang, H.H.; Zhang, H.B.; Zhong, M.J.; Ma, L.Y.; Liu, D.S.; Liu, W.Z.; Ren, H. Potential antiviral xanthones from a coastal saline soil fungus Aspergillus iizukae. Mar. Drugs 2018, 16, 449. [Google Scholar] [CrossRef] [Green Version]
- Zhao, Y.; Liu, J.P.; Lu, D.; Li, P.Y.; Zhang, L.X. A new antioxidant xanthone from the pericarp of Garcinia mangostana Linn. Nat. Prod. Res. 2010, 24, 1664–1670. [Google Scholar] [CrossRef] [PubMed]
- Li, P.; Yang, Z.; Tang, B.; Zhang, Q.; Chen, Z.; Zhang, J.; Wei, J.; Sun, L.; Yan, J. Identification of xanthones from the mangosteen pericarp that inhibit the growth of Ralstonia solanacearum. ACS Omega 2020, 5, 334–343. [Google Scholar] [CrossRef] [PubMed] [Green Version]

| Extract | Mass of Extract Obtained | 1 CFU/mL | % Inhibition Compared to Control | |
|---|---|---|---|---|
| NF17 | 7 mg | 24.80 | e 2 | 70.89 |
| NFrCs16 | 3.7 mg | 55.40 | d | 34.98 |
| NFrCs4 | 3 mg | 71.20 | c | 16.43 |
| NFrCs8 | 5.4 mg | 74.40 | c | 12.68 |
| NC4 | 3 mg | 75.00 | c | 11.97 |
| NC10 | 8 mg | 80.00 | c | 6.10 |
| NFrS2 | 7 mg | 82.40 | c | 3.29 |
| Control | 10 mg | 85.20 | c | - |
| NC5 | 8 mg | 89.80 | b | - |
| NR7 | 24 mg | 102.80 | a | - |
| Isolate | Species |
|---|---|
| NF17 | Guignardia mangiferae |
| NC4 | Macrophoma theicola |
| NC5 | Macrophoma theicola |
| NC10 | Trichoderma longibrachiatum |
| NFrCs4 | Diaporthe phaseolorum |
| NFrCs8 | Macrophoma theicola |
| NFrCs16 | Fusarium proliferatum |
| Strains | Sample | ||
|---|---|---|---|
| ACN ext | S1 | S2 | |
| PA4.3 | 50.0 (-) | 50.0 (-) | 12.5 (-) |
| PA5.2 | 3.125 (-) | 25 (=); 3.125 (-) | 3.125 (=) |
| PA18 | 12.5 (=) | 12.5 (=) | 25.0 (=) |
| PA20 | 3.125 (-) | 50.0 (=); 12.5 (-) | 100.0 (=), 25.0 (-) |
Publisher’s Note: MDPI stays neutral with regard to jurisdictional claims in published maps and institutional affiliations. |
© 2022 by the authors. Licensee MDPI, Basel, Switzerland. This article is an open access article distributed under the terms and conditions of the Creative Commons Attribution (CC BY) license (https://creativecommons.org/licenses/by/4.0/).
Share and Cite
de Oliveira, L.C.; da Costa, W.C.L.; Vinagre, V.G.; Siqueira, J.E.d.S.; Silva, S.d.C.; Silva, S.Y.S.; Marinho, A.N.d.R.; Rocha, D.C.d.C.; Marinho, P.S.B.; Nakasone, A.K.; et al. Bioprospecting the Antibacterial Activity of Endophytic Fungi from Noni (Morinda citrifolia) against Bacterial Spot of the Passion Fruit Tree. Agronomy 2022, 12, 1690. https://doi.org/10.3390/agronomy12071690
de Oliveira LC, da Costa WCL, Vinagre VG, Siqueira JEdS, Silva SdC, Silva SYS, Marinho ANdR, Rocha DCdC, Marinho PSB, Nakasone AK, et al. Bioprospecting the Antibacterial Activity of Endophytic Fungi from Noni (Morinda citrifolia) against Bacterial Spot of the Passion Fruit Tree. Agronomy. 2022; 12(7):1690. https://doi.org/10.3390/agronomy12071690
Chicago/Turabian Stylede Oliveira, Luana Cardoso, Williams Carlos Leal da Costa, Viviane Garcia Vinagre, José Edson de Sousa Siqueira, Sebastião da Cruz Silva, Simone Yasue Simote Silva, Anderson N. do Rosario Marinho, Daniela Cristiane da C. Rocha, Patrícia Santana Barbosa Marinho, Alessandra Keiko Nakasone, and et al. 2022. "Bioprospecting the Antibacterial Activity of Endophytic Fungi from Noni (Morinda citrifolia) against Bacterial Spot of the Passion Fruit Tree" Agronomy 12, no. 7: 1690. https://doi.org/10.3390/agronomy12071690
APA Stylede Oliveira, L. C., da Costa, W. C. L., Vinagre, V. G., Siqueira, J. E. d. S., Silva, S. d. C., Silva, S. Y. S., Marinho, A. N. d. R., Rocha, D. C. d. C., Marinho, P. S. B., Nakasone, A. K., & Marinho, A. M. d. R. (2022). Bioprospecting the Antibacterial Activity of Endophytic Fungi from Noni (Morinda citrifolia) against Bacterial Spot of the Passion Fruit Tree. Agronomy, 12(7), 1690. https://doi.org/10.3390/agronomy12071690

